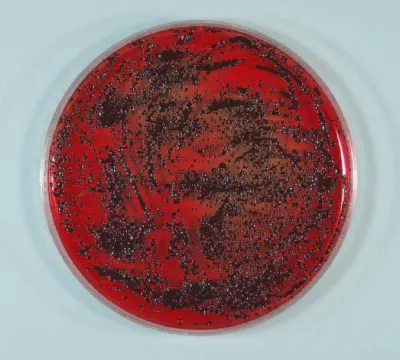
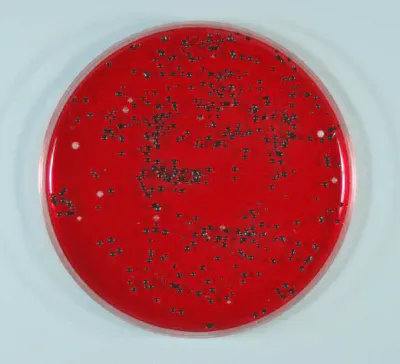

はじめに・ご挨拶
はじめまして。
頑固な口臭を効果的に改善する歯磨き剤「美息美人(びいきびじん)」を開発した株式会社アイオーンの上林(61歳のおじさん)です。
このページをご覧いただきありがとうございます。
人気の口臭ブログ(https://detoxit.jp/b/)を書いていますので、読者の皆様には知られているかと思います。
そんな株式会社アイオーンが、10年目にして初めて「美息美人」をリニューアル販売することとなりました。
「美息美人ってなに?」と思われる方も多いかと思いますので、以下で「美息美人」の紹介と、商品開発までの経緯をご説明させていただきます。
プロダクトのご紹介
美息美人(びいきびじん)って何?
美息美人は、口臭を防ぐための歯磨き剤です。
これだけでは、「歯磨き粉なんてどこにもあるよね。」と思うかもしれません。口臭予防の歯磨き粉といっても、「今まで何をしても治らなかった」方のために開発した歯磨き粉、それが一番のウリです。
実績の参考⇒ https://biikibizin.co.jp/SHOP/rating_list.html
【無添加歯磨き粉】
歯磨き粉といえば、チューブの歯磨きが一般的ですよね。そして、泡が立ちいい香りがする。ところが、美息美人は、泡が立たなければ香りもしません。(見た目は水と同じ)
ホタテ貝殻パウダーを主成分とした無添加歯磨き粉だからです。
※成分:ホタテ貝殻、クエン酸、水(合成界面活性剤、研磨剤、香料、発泡剤等が無添加)
【歯が強くなるアパタイト成分】
美息美人はホタテ貝殻から作られているため、歯と同じアパタイト(カルシウムとリン)がイオン水の中に溶け込んでいます。
そのため、美息美人で歯磨きを行えば、自然と歯が強くなります。(※一般的な歯磨き粉の場合には、フッ素でコーティングする)
美息美人で歯磨きを行うと、歯がツルツルになるので驚かれるかもしれません。
【アルカリイオン水】
「水で歯磨きができるの?」水といっても、PH10.5のアルカリイオン水なので、虫歯や歯周病などの原因となるプラークを溶かして落とすことができます。
(※アルカリの重曹でうがいを行うと、口臭予防になると言われていますが、重曹水のPHはPH8.3。美息美人の濃度は、重曹水の100倍もあります。)

【歯周病菌への効果】
(財)日本食品分析センターの試験では、歯周病菌(ジンジバリウス菌)を美息美人の容器の中に30分入れておくと、ほとんどが死滅しました。

試験開始(黒い粒が歯周病菌)

5分後
15分後
30分後(歯周病菌はほとんどありません)
[安全性試験](財)日本食品分析センター
・皮膚一時刺激性試験(長く触れたときの炎症)での刺激反応は0
・急性経口毒性試験でも人体に問題なし
・常在菌の真菌カンジダには影響なし
強アルカリは熱傷を起こすといわれますが、美息美人は自然のホタテ貝殻だけを使用し特殊製法で作られているために、細菌には影響を与えるが人体には無害だということが証明されています。だから安心して歯磨きができます。
【口臭予防の効果】
歯の治療をしても、ていねいに歯磨きをしても、口臭が治らないのはどうしてだと思いますか?
口臭は、歯(歯茎)と舌と喉から発生します。そして、口と喉は隣りあわせ。だから、歯(歯茎)からの臭いを予防しても、口臭はなくなりません。
口臭がしないようにするためには、歯(歯茎)と舌と喉のケアが必要です。
口臭の6割以上が舌の苔(舌苔ぜったい)から発生し、1割未満が喉に原因があります。(※喉粘膜に臭い粘液が付着している)
「口臭が治らない」のは、舌と喉のケアが出来ていないからです。完全に口臭をシャットアウトするには、、、歯周ポケット内のプラーク、舌苔、喉の粘液、を取り除く必要があるのです。それを期待できるのが、美息美人のアルカリイオン水です。
「美息美人を使うとどうして口臭が治るの?」
美息美人のアルカリイオン水は、歯磨きとうがいの両方に使えるからです。
効果の参考⇒ https://biikibizin.co.jp/SHOP/rating_list.html
美息美人が口臭を防ぐ理由
口臭の6割以上は舌苔が原因です。そのため、ブラシで舌を磨いている人がいますが、舌磨きは舌を傷めて口臭を逆に悪化させるのをご存知でしょうか。
舌苔はアルカリイオン水で溶かして除去!
何をしても口臭が治らない場合は、喉にたまる膿栓(臭い玉)と膿汁(痰のような粘液)が原因のことが多いのです。そのような口臭を防ぐためには、喉を清潔にすることが重要です。
このような喉からの口臭にもアルカリイオン水が作用します。

使用方法
1、コップにボトルを一振りする(適量が出ます)
2、コップに水道水を満タン入れます。
3、アルカリイオン水でうがい
4、口と喉のうがい
5、通常通り歯磨きを行う。(うがいと歯磨きを繰り返す)
美息美人(アルカリイオン水)の作り方と使い方は、たったこれだけ!
プロダクト誕生まで
口臭予防歯磨き粉「美息美人(びいきびじん)」を開発した上林です。
40歳台の後半から歯周病になり、会話すると、相手の人が鼻を触るようになりショックでした!明らかに、口が臭いというサインです。
その仕草は、口臭を気にしている私にとっては、とても辛いことでした。
また、ヒソヒソ話をしているのを見ると、まるで自分のことを噂されている気になり、屈辱感を持つようになったものです。
今思い出すと、こんなこともありました。デスクワークをしていると、部下の女性がガムを私にくれました。気を遣って遠回しに教えようとしたのかもしれません。
また、私が車に乗ると、毎回少しだけ窓を開ける運転手もいました。
この頃からです。人と話しをする自信がなくなっていったのは。そして、この時から、わたしの口臭との戦いが始まったのです。
初めの内は、口臭がするのは「歯みがきが出来ていないからなのだろう。」と思っていたので、朝夜歯磨きをするようにしましたが、口臭はなくなりませんでした。
まだ歯みがきが足りないのだろうかと、昼食後も歯みがきをするようにしましたが、ただの自己満足でした。
仕方なくガムでごまかしたり、口臭予防のサプリを飲んでみたり…。こんなことをしても解決しないのは分かっていたのですが、ほかに方法はありませんでした。
それからです。いい歯磨き粉を探すためにドラッグストアを巡ったのですが、そんな努力をしても、結果はむなしく。。。。
当然ですよね。何をしても治らなかった口臭が、そんなに簡単に解決するはずがありません。もっと早く気付くべきでした。この時は、半分あきらめかけていました。
ところが、奇跡が起きたのです。
飛び込みのセールスマンからホタテ貝殻エキスの消毒剤を知ることになりました。ホタテ貝殻エキスの殺菌効果の説明を受け、「もしかすると私の口臭も治るのでは?」と、ふと思ったのです。
ものは試しと、ホタテ貝殻エキスで歯磨きをしてみると直ぐに効果が。使った翌朝、驚くほど口のネバネバが無くなっていました。
これは続ける価値があるなと思い、口臭が治るかもしれないという期待から歯ブラシが楽しくなりました。
5日ほど続けてから、嫌がる娘に私の口のにおいを嗅いでもらうと、「臭くないよ。」この言葉がどんなに嬉しかったことか、今でもはっきりと憶えています。
その後、ホタテ貝の効果はどんどんと表れました。周囲の反応も変わりましたが、口のネバネバがなくなりスッキリ!あきらかに口臭が改善されたと実感できました。それに、歯茎がピンク色になり知覚過敏も治ったりと、ホタテ貝の効果には本当に驚かされました。
それからです。「こんな良い歯磨き粉を独り占めしてはいけない。」「他の人にも教えてあげたいな。」「もっと多くの人たちのお役に立てないだろうか?」と、大きな夢を描くようになったのです。
※こちらの動画をご覧ください。「どうして美息美人が口臭に効くのか?」が分かります。
定期検診のときに歯医者さんから「最近、歯がきれいですが、何かしましたか?」と、尋ねられたのです。嬉しくて、「はい。実は、ホタテ貝殻を使った歯磨き粉を使用しているのですが、とてもいい感じなんです。」と答えると、、、
歯医者さんから「へえ~、詳しく教えてほしいですね。」と奥の部屋に呼ばれ。歯磨き粉を使ってもらった友人や知人の話をすると、ホタテ貝殻の歯磨き粉に大変興味を持ってくれました。
そして、臨床テストまでしてもらえることにまでなり、あまりにもテスト結果が良かったので、歯医者さんから「販売したらどうですか?」と勧められるまでに。




本気で商品化しようと考えるようになったのは、この時からです。「でも、商品化するには、もっと多くの不特定多数の人の素直な意見も聞きたい。」
そういう考えからネットでモニターを募集しました。モニターに応募してくれた人たちが口臭で困っていたので、素直な感想や要望を仰ってくださいました。
1週間から2週間という短いモニター期間でしたが、「歯がツルツルになった。」「口臭が改善した。」「朝起きた時、口の中がすっきりしている。」「歯茎が引き締まった。」それどころか、「歯茎からの出血がとまった。」という方もおられました。
しかし、モニターテストの結果は…いい回答ばかりではありませでした。中には、「生臭いにおいがするから嫌。」(※新商品は、この臭いをしないように改良)
「泡立ちがないので不安。」、「そのまま使えないので面倒。」と、いうような感想もあり、「効果は認めてくれたが、買ってもらえないかも…」という不安がありました。
そう信じて商品化へ突き進んだのですが、進めば進むほどいばらの道の連続でした。直ぐに30社ほど代理店が集まったのですが、専門的な説明ができないとの理由から全員やめられたのです。
こんなこともありました。代理店の歯科材料店さんが歯科医院に営業に行ったときに、「そんなモノで歯周病が治るのなら、歯医者はいらなくなる!」と言われたと、不満を私にぶつけてきました。
心が折れそうになった時、私を救ってくれたのはモニターの方からの感謝の声でした。「今まで一向に口臭が治らなかったのですが、美息美人を使用してから口臭が改善されました。」(個人の感想です。)
効能や効果を書くには薬事法の手前、ここでは詳しく申し上げられないのですが、大事なのは結果です。→ https://biikibizin.co.jp/SHOP/rating_list.html
お客様から、そのことを教えられたのです。私がやろうとしていたのは、口臭で悩んでいる人のための歯磨き粉を作ることです。
信念を貫かないといけない。口臭を改善したいと悩んでいる人のために、こんなことで負けてはいけない。そう思って立ち直ったのです。
その結果、現在では3万人以上の人に美息美人を使っていただけることになったのです。感謝しかありません。
口臭が改善する理由
私自身、咳がよく出る体質でしたが、美息美人のイオン水でうがいを実行するようになってからは、咳が激減したのです。すぐに、お客さまにも喉うがいを勧めると、「良くなった!」と多くの方に喜ばれました。
今では、喉口臭の方には「歯磨きだけではなく美息美人のアルカリイオン水でゴロゴロうがいを一回5秒、一日2回うがいしてみてください。」とアドバイスするようにしています。
すると、数日後には、「あれほど治らなかった口臭が、嘘のように治りました。」と、喜びのメールが送られてきます。(ケースによっては、これだけでは治らない場合もあります。)
こんなに簡単で、口臭外来にかかる費用よりはるかに安く、(※歯磨き1回あたり約13円)そして、短期間で口臭を改善できるなんて今までは不可能でした。
それが、口臭予防歯磨き粉「美息美人」で解決されたのですから有難いことです。
また、舌苔で取れず困っていたお客様からは、「コットンに美息美人を湿らせて舌を拭くと、舌苔が取れました。」と教えていただきました。
嬉しくて、直ぐに他のお客さまにもその方法を紹介すると、次から次へと「舌がピンクになりました。」と感謝のメールが来るように。
美息美人の良さをお客様が引き出してくれたのです。
今回の改良により、その美息美人をさらに使いやすく出来たことで、もっと多くの人たちに喜んでもらえるだろうとワクワクしています。
※個人の感想ですので、効能・効果を保証するものではありません。
そして、何よりも、私自身が初めて美息美人を使った時の感動を、皆様にも味わって頂きたいと思います。
お話が長くなってしまいましたが、是非ともクラウドファンディングへのご支援の程よろしくお願い申し上げます。
★美息美人を世界中に広めるという理念に共感され、一緒に販売活動(アフィリエイト)を行って頂ける方を募集しています。詳しくは、リターン要綱をご参照ください。
リターンのご紹介
①口臭予防歯磨き粉「美息美人」(定価4,700円、送料、税込み)
②【高血圧改善の方法】
高血圧だった私が実践して、血圧155/110→116/73になった方法です。
③【ハゲの予防方法】
毎朝、枕に髪の毛が抜けて頭頂部から前方が透けて見えていたのが、抜け毛が止まり髪が増えた方法です。(私が実践ずみの方法)
④【口臭相談1回】(メール)
口臭の悩みをメールでご相談ください。1万人近くのお客さまに答えてきた上林が親身になりアドバイスさせていただきます。
⑤アフィリエイト参加権利(30%報酬率)
口臭予防歯磨き粉「美息美人」のアフィリエイトプログラムへの参加権利です。アフィリエイト報酬率が30%と高く、ブログやメルマガなどを配信している方であれば、誰にでも収益のチャンスがあります。
【アフィリエイタープログラム参加の手順】
1、購入者へメールで「アフィリエイトプログラム」申込みフォームURLを送ります。
2、申込画面からアフィリエイター登録。
3、登録後にID、パスワードを利用して「アフィリエイター画面」へログイン。
4、紹介したい商品の「タグ」をアフィリエイター自身のホームページ、またはメルマガなどに挿入して公開。
5、アフィリエイターのホームページ経由で商品が購入された場合に成果報酬の支払い
※毎月、メールにて成果報酬の連絡があります。
製品情報・仕様
口臭予防歯磨き粉「美息美人」
内容量:10g(1日2回の使用で約6か月使える量)
成分:ホタテ貝殻パウダー(青森県産)、クエン酸(原料は鹿児島産のさつまいも)、水
メディア掲載
ブログの執筆だけでなくYouTubeでも人気。代表作はこちらをご参考にしてください。
舌を傷付けない「舌苔の除去法!」 19万回視聴
膿栓(臭い玉)を取ってはいけない本当の理由 11万回視聴
歯茎の腫れと出血は歯ブラシで治せる 97,680 回視聴
歯周病による口臭!歯磨きで完全なまでに消滅させる方法 80,806 回視聴
口臭がドブ臭・うんこ臭の対策方法 129,424 回視聴
究極!リアル口臭チェック 34,769 回視聴
どこでも簡単!すぐに!口臭を消す方法 11,065 回視聴
※視聴回数は、2019,10,8時点
◆Q&A
<All-in方式>
本プロジェクトはAll-in方式で実施します。目標金額に満たない場合も、計画を実行し、リターンをお届けします。
Q:送料はかかりますか?
A:リターン(特典)の金額に、送料も含まれております。
※お届けができず弊社に戻ってきてしまった場合は、再配送費用をご負担いただく可能性がありますことをご了承ください。
Q:以前に購入した美息美人との違いはありますか?
A:今までの美息美人には、アルカリ独特のニオイや刺激がありました。リニューアルした新製品は、効果はそのままでニオイや刺激を抑えているので、安心してご使用できます。
Q:アフィリエイトプログラムへの登録はどのようにするのですか?
A:ご支援申し込み時に教えて頂いたメールアドレス宛に、アフィリエイト登録ページURLをお伝えします。
◆クラウドファンディングにおけるリスク・諸注意
※デザイン・仕様は変更になる可能性もございます。
※想定を上回る大量のご注文時や素材供給に時間が必要な場合など予期しないトラブル、また物流事情などで遅延が発生する場合がある点についてはご留意ください。
※指定期日までに正しいお届け先住所を入力いただけなかったなどの間違い、受け取り漏れなどお客様都合による配送トラブルによって再配送が必要な場合の送料はお客様のご負担となりますので、あらかじめご了承くださいませ。
※キャンセル・返品: 当プロジェクトは「All-in型」の為、お申込み完了をもって契約が成立いたします。その為、お客様都合による返品・キャンセルはできませんのでご注意ください。尚、製品到着後に破損や初期不良がある場合には交換させていただきますので「メッセージで意見や問い合わせを送る」から、または納品書記載の連絡先までお問い合わせください。
◆特定商取引法に関する記載
◯ 販売事業者名
株式会社アイオーン
◯ 事業者の所在地
〒547-0021
大阪府大阪市平野区喜連東3-11-33-303
◯ 事業者の連絡先
123@ueb-a.com
※こちらのメールではお申し込みは受け付けておりません。お問い合わせは当ページの「メッセージで意見や問い合わせを送る」ボタンよりお願い致します。
◯ リターン価格
各リターン記載の通り
※商品内容に関してはリターン欄記載の通り
◯ 申込期限
当ページ記載のプロジェクト終了期限通り
◯ 支払い方法
・クレジットカード払い(Visa/Mastercard/JCB/Diners Club/American Express)
・コンビニ払い(全国の主要コンビニエンスストア)
・銀行振込(銀行ATM・ネットバンキング)
・auかんたん決済/ソフトバンクまとめて支払い・ワイモバイルまとめて支払い/ドコモ払い
※こちらのクラウドファンディングは全て、220円のシステム利用料がお支払い金額に合算されます。
◯ 支払い時期
当プロジェクトは「All-in型」の為、目標達成の如何に問わず、ご契約が成立します。その為、お申込みと同時にご利用の決済方法に準じてご請求となります。
◯ 引渡し時期
各リターン詳細に記載の発送予定日を引き渡し時期とします。但し、開発・生産状況によって遅れが生じる場合がありますのでその際は当プロジェクトページ内の「活動報告」または購入者へのメール等で連絡します。
◯ キャンセル・返品
当プロジェクトは「All-in型」の為、お申込み完了をもって契約が成立いたします。その為、お客様都合による返品・キャンセルはできませんのでご注意ください。
尚、製品到着後に破損や初期不良がある場合には交換させていただきますので「メッセージで意見や問い合わせを送る」から、または納品書記載の連絡先までお問い合わせください。
★口臭予防歯磨き粉「美息美人」の通販ショップの特定商取引法に関する表示
https://biikibizin.co.jp/hpgen/HPB/shop/business.html
最新の活動報告
もっと見る舌が白い:症状・原因・対策・舌ケア
2020/03/19 11:08舌が白いと、口臭がきつくなるなどトラブルが起こるため、気になっているのではないでしょうか?今回の記事は、口臭の原因となる舌苔対策について、専門家の立場からアドバイスしたいと思います。舌苔ができると、口臭の他にも多くのトラブルが起きてきます。そのようなことにならないように、舌の異常からおきる症状と原因を理解して適切な対策をしましょう。【舌の色について】健康な人の舌の色は、ピンクの舌の上に薄っすらと白い膜が張った感じですが、体調不良や口腔内の不衛生から舌苔ができて、舌が白く(または黄色)なります。※舌のしこりや痛みなど症状が治らない場合は、病気の可能性もあるので受診するようにしてください。舌が白くなると次のような症状がおこります。【症状】・舌に分厚い舌苔がついている・舌苔がまだらの地図状になっている・舌が黄色・口臭が強い・口が苦い、口がまずい・口がネバネバ・口が乾く・舌に溝ができる、ひび割れができる・食べ物の味が分からない、味覚障害【原因】舌が白いのは、舌の上に舌苔というモノが着いているからです。舌苔は細菌がつくるプラークです。(歯のプラークと同じもの)舌乳頭の先が固くなり、舌のザラザラした凹みに食べかすや細胞の死がいがたまると、細菌がそれをエサにするために集まって舌苔ができます。(※舌乳頭の角化は、胃腸障害から起きやすいです。)嫌気性細菌は、舌苔のタンパク質を分解して臭いの元となるVSC(揮発性硫黄化合物)を産生するため、舌を黄色くし、口臭を発生させることになるのです。また、舌苔ができやすい場合には、元々唾液が少ないドライマウスの人が多いので、口が粘つくとか、口が乾くことに。舌の溝(ひび割れ)ができるのも舌の乾きが原因です。唾液中にVSC(揮発性硫黄化合物)が溶け込むと口が苦くなり、唾液がネバネバすることで味がまずくなります。それだけではありません。味を感じる味蕾を舌苔が覆い被さると、食べ物の味が分からなくなる味覚障害を起こすこともあります。【対策】・舌苔が出来た時の対処法は… 歯磨きやうがいで口内を清潔にすることが大切ですが、分厚い舌苔がある場合には、舌ブラシで舌を磨いて舌苔を取り除くことも大事です。・ドライマウスの予防は… 唾液量を増やすことが大切です。唾液量を増やすためには、咀嚼回数を多くする、会話する、水を飲むことが大事です。他に、いびきや口呼吸がある時は、改善の努力が必要です。また、意外かもしれませんが、降圧剤などお薬の副作用やストレスが唾液量の減少に影響しているケースが多いので、その対策が必要なことも。・舌苔の予防は… 東洋医学では、舌が白くなる(舌苔が着く)のは、体調不良のサインだといわれています。舌苔を予防するためには、心身ともに健康であることが大切です。健康を維持するためには、栄養バランスのとれた食事や野菜など繊維の多い食べ物で胃腸を強くする、そして、規則正しい生活(睡眠や運動も)、ストレスの少ない生活を心掛けることが、舌苔対策では重要なことです。【舌ケア】舌をきれいにするには、舌磨きをして舌苔を取り除きますが、気を付けないといけないのは、舌の磨き過ぎです。舌粘膜を傷付けると舌苔が治らず逆効果になるのでご注意ください。舌磨きしないほうがいい理由は、こちらをご参考にしてください。舌の磨き方は、専用の舌ブラシを使うのが良いです。舌の奥から優しくなぜるように2~3回磨いてください。舌が乾燥する場合には、あらかじめ舌ジェルを塗布してから舌清掃をするといいです。また、舌清掃の後も、舌ジェルを塗ることで保湿効果があります。舌清掃をする前に、アルカリイオン水でうがいをしてから舌を磨くと、舌苔が良く取れるのでおすすめします。また、アルカリの作用で口臭予防になります。詳しくは、こちらをご覧ください。。>>口臭の原因「舌苔」を落とし予防する方法を知っていますか? もっと見る口臭対策は社会人のエチケット!でも歯磨きだけでは不十分かも?
2020/02/16 12:15「口臭対策は社会人としてのマナー!」というか、口臭があると周囲から避けられるかもしれません。実際、口臭があると、仕事や恋愛などで損をすることまであります。そういうことから、口臭を気にしている人は、日本人(成人)の8割以上もあるそうです。(日本歯科医師会発表)この記事を読まれているあなたも、口臭がしないよう、歯磨き剤、マウスウォッシュ、デンタルリンス、タブレットと口臭対策グッズに気を配っているのではないでしょうか。しかし、口臭予防にそれだけ努力しても、爽やかな息にならないのはどうしてだと思いますか?効果的に口臭対策をするには、口臭の原因を理解することが大事です。このように言うと難しそうですが、分かってしまうと「口臭を予防するのって簡単なんだ。」と思うでしょう。口臭原因の90%~98%がお口の中にあります。歯に付いている歯垢が原因です。歯垢には細菌が無数あり、細菌が口の中の汚れを分解して腐敗臭(口臭)を発生しているのです。ですから、口臭を予防するためには、歯垢(細菌)を除去しないといけないのですが、細菌が潜んでいるのは、狭い歯周ポケットの中や舌のヒダの間。どこも、歯磨きのできない場所です。それでも、口臭のしない人がいるのは何故でしょう?口臭のない人たちは唾液の分泌量が多く、口臭菌をコントロールしているのです。口臭を予防するためには、たくさん唾液を出してお口を乾かないようにするのが一番です。でも、唾液が出ないことが口臭対策の一番のネックですよね。それだけではありません。人の何倍もブラッシングなど口腔ケアを行っている人がいます。それでも口臭がするのはどうしてでしょう?それは、鼻や喉に炎症があり細菌が増殖しているからです。喉と口は隣り合わせですから、細菌も自由に行き来します。この細菌が舌や歯に着き口臭を作っているのです。もう答えは分かったと思います。効果的に口臭対策をおこなうには、お口(歯・舌)と喉を清潔にすると良いのです。具体的には、ブラッシングケアを十分にして、舌のケアをする。口臭ケアのポイントは、この2つがいかにできるかということになります。詳しくはこちらを参考ください>>簡単にできる口臭ケア!ポイントは4つ舌苔のケア→ 舌が白い!舌苔の治し方って知っていますか? その方法でおすすめしている口腔ケア剤が、「美息美人(びいきびじん)」です。美息美人は、アルカリイオン水で歯磨きとうがいに使用でき、また、アルカリの作用で歯垢や口臭原因菌を溶かしながら除去できるのが特徴です。でも、「アルカリイオン水は、美息美人でなくても良いのでは?」と思いませんか。それに、「アルカリイオン水で本当に舌苔が取れるのだろうか?」と疑いたくなりますよね。そのような疑問がすべてこちらの記事で解決できますので、今すぐご覧になってください。>>舌が白い!!それならアルカリイオン水でうがい!?お口がスッキリするとストレスが減り、唾液の分泌が良くなるという報告も沢山あります。口臭予防歯磨き粉「美息美人」について詳しくは、こちらをご参考にしてください。→ https://biikibizin.co.jp/SHOP/biikibizin12-6.html もっと見る40名達成しました!感謝!感謝!
2020/01/30 13:48CAMPFIREパトロンおよびページを拝見されてる皆様へ、開始から24日目ですが、40名の方からのご支援をいただきました。これも皆様のサーポートのおかげです。ありがとうございます。さて今回の活動報告では多くの皆様からご質問をいただいた口臭予防に関して皆様とシェアさせて頂こうと思います。口臭といえば、歯の汚れ「歯垢」が原因だと思われていますが、実は舌の汚れ「舌苔(ぜったい)」が口臭原因になっていることの方が多いのです。日本歯科医師会でも、「口臭の6割以上が舌苔に原因」だと発表されています。ですので、口臭を予防するためには、舌の汚れを除去しないといけません。ところが、舌ケアをされている方の多くが、歯ブラシ(舌ブラシ)で舌をゴシゴシと磨いています。この行為が舌乳頭を削ってしまい、かえって舌苔をつくり口臭を悪化させてしまっているのです。では、白くなった舌をきれいにするためには、どうすれば良いのでしょう?簡単です。舌磨きをやめれば綺麗になります。本当でしょうか?舌磨きをやめないといけませんが、それだけでは口内環境を改善できないため、また舌が白くなります。舌苔が再度付かないようにするには、口内の汚れと細菌を洗い流すことも大切なのです。そのための「美息美人」のアルカリイオン水です。こちらの記事をご参考にしてください。舌磨きは絶対にしてはいけない!なぜなら口臭をひどくする原因だからです。どうしたらいいかというと・・・ もっと見る





コメント
もっと見る